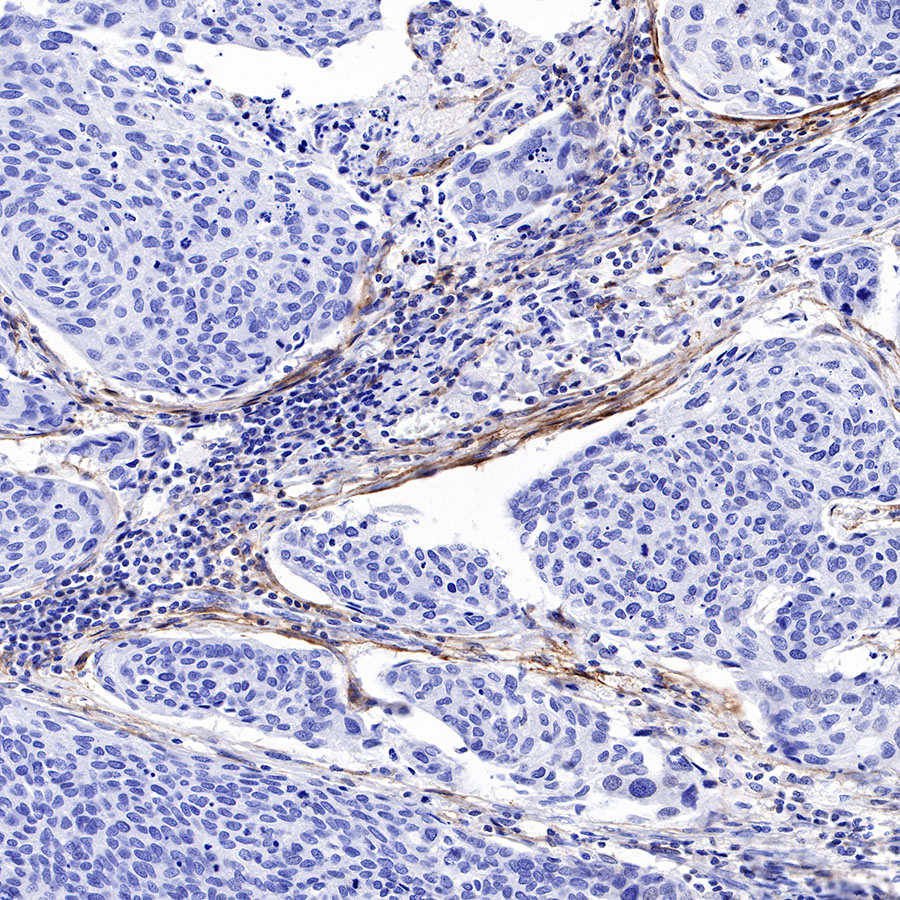

Product Details
Product Details
Product Specification
| Host | Rabbit |
| Antigen | FAP |
| Synonyms | Prolyl endopeptidase FAP, 170 kDa melanoma membrane-bound gelatinase, Dipeptidyl peptidase FAP, Fibroblast activation protein alpha, Gelatine degradation protease FAP, SIMP, Seprase |
| Immunogen | N/A |
| Location | Cell membrane, Cell Surface |
| Accession | Q12884 |
| Clone Number | SDT-R132 |
| Application | WB, IHC-P |
| Reactivity | Hu |
| Purification | Protein A |
| Concentration | 0.5 mg/ml |
| Physical Appearance | Liquid |
| Storage Buffer | PBS, 40% Glycerol, 0.05% BSA, 0.03% Proclin 300 |
| Stability & Storage | 12 months from date of receipt / reconstitution, -20 °C as supplied |
Dilution
| application | dilution | species |
| WB | 1:1000 | null |
| IHC-P | 1:500 | null |
Background
Fibroblast activation protein (FAP) is best known for its heightened expression in tumour stroma. This atypical serine protease has both dipeptidyl peptidase and endopeptidase activities, cleaving substrates at a post-proline bond. FAP expression is difficult to detect in non-diseased adult organs, but is greatly upregulated in sites of tissue remodelling, which include liver fibrosis, lung fibrosis, atherosclerosis, arthritis, tumours and embryonic tissues. Due to its restricted expression pattern and dual enzymatic activities, FAP is emerging as a unique therapeutic target [PMID: 24470260].
Picture
Picture
Western Blot

WB result of FAP Rabbit mAb Primary antibody: FAP Rabbit mAb at 1/1000 dilution Lane 1: SK-MEL-28 whole cell lysate 20 µg Lane 2: HFF whole cell lysate 20 µg Low expression control: SK-MEL-28 whole cell lysate Secondary antibody: Goat Anti-Rabbit IgG, (H+L), HRP conjugated at 1/10000 dilution Predicted MW: 87 kDa Observed MW: 95 kDa
Immunohistochemistry

IHC shows positive staining in paraffin-embedded human lung squamous cell carcinoma. Anti-FAP antibody was used at 1/500 dilution, followed by a HRP Polymer for Mouse & Rabbit IgG (ready to use). Counterstained with hematoxylin. Heat mediated antigen retrieval with Tris/EDTA buffer pH9.0 was performed before commencing with IHC staining protocol.
IHC shows positive staining in paraffin-embedded human cervical squamous cell carcinoma. Anti-FAP antibody was used at 1/500 dilution, followed by a HRP Polymer for Mouse & Rabbit IgG (ready to use). Counterstained with hematoxylin. Heat mediated antigen retrieval with Tris/EDTA buffer pH9.0 was performed before commencing with IHC staining protocol.

IHC shows positive staining in paraffin-embedded human colon cancer. Anti-FAP antibody was used at 1/500 dilution, followed by a HRP Polymer for Mouse & Rabbit IgG (ready to use). Counterstained with hematoxylin. Heat mediated antigen retrieval with Tris/EDTA buffer pH9.0 was performed before commencing with IHC staining protocol.

Negative control: IHC shows negative staining in paraffin-embedded human liver. Anti-FAP antibody was used at 1/500 dilution, followed by a HRP Polymer for Mouse & Rabbit IgG (ready to use). Counterstained with hematoxylin. Heat mediated antigen retrieval with Tris/EDTA buffer pH9.0 was performed before commencing with IHC staining protocol.
